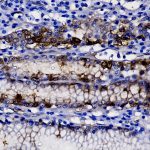
AMB39

|
|---|
 Anti-Galectin-3, Clone B2C10 Anti-Galectin-3, Clone B2C10Buy here |
 Anti-Gastrin Anti-GastrinBuy here |
 Anti-GATA-3 [GATA3/6664] Anti-GATA-3 [GATA3/6664]Buy here |
 Anti-GATA-3 [HG3-31] Anti-GATA-3 [HG3-31]Buy here |
 Anti-GCDFP-15 Anti-GCDFP-15Buy here |
 Anti-GCDFP-15 Anti-GCDFP-15Buy here |
 Anti-GCDFP-15 and TTF-1 Anti-GCDFP-15 and TTF-1Buy here |
 Anti-GH Anti-GHBuy here |
 Anti-GH Anti-GHBuy here |
 Anti-GITR Anti-GITRBuy here |